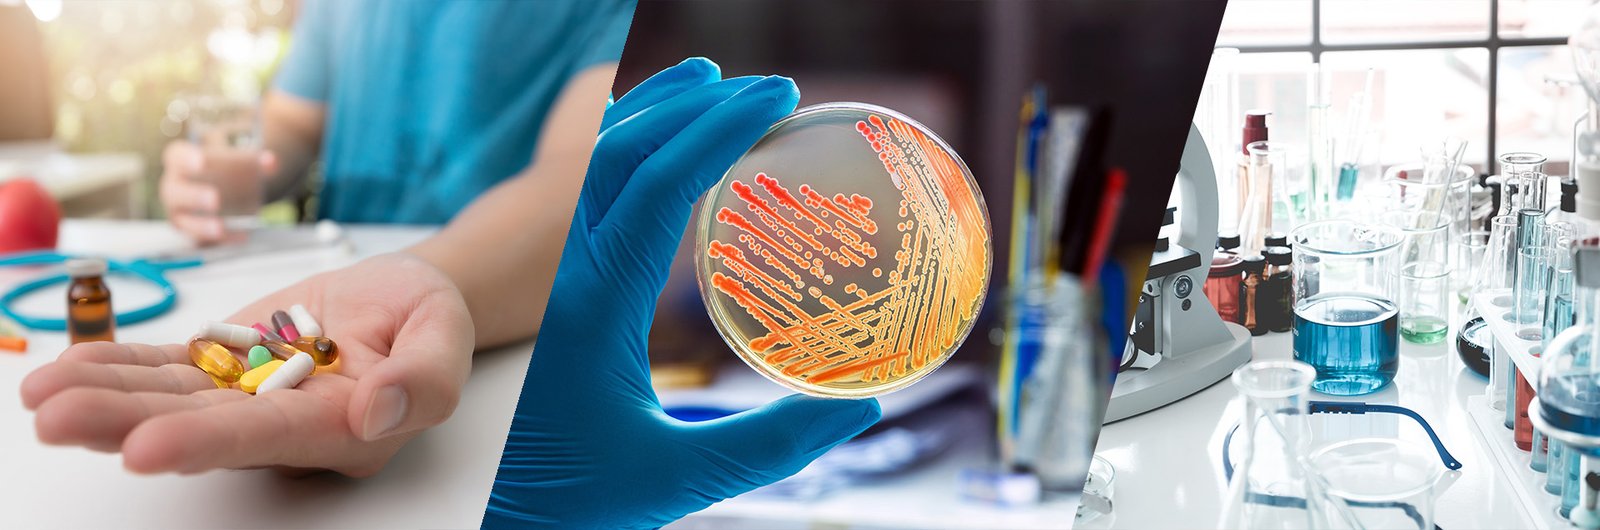

About Us
Eureka Analytical Services (Eureka) is a provider of leading testing, inspection and auditing services for food, agricultural commodities, feed, nutraceuticals, pharmaceuticals and the environment, with labs in Bangalore, Kundli-Delhi, Unjha, Gujarat, Guntur-Andhra Pradesh, Bramer, Kerala, Kolkata, Sangli, Sri City and Mumbai, all of which are recognized by NABL, APEDA, EIC, BIS, FSSAI, Spice Board, IOPEPC, the Tea Board, GMP+ and the FDA at different sites.
Eureka was founded by professionals with a long and successful track record of building and leading such businesses in the TIC (Testing-Inspection-Certification) industry. The experience of our staff combined with the latest technology helps provide a comprehensive portfolio of analytical methods in every segment.
Eureka is the exclusive member lab in the Indian sub-continent, of the GBA Group, headquartered in Hamburg, Germany (www.gba-group.de/en). GBA Group is a leading bioanalytical testing company in Europe, offering a suite of reliable and comprehensive analytical services. The Group has built a global network of testing laboratories and competence centers. These perform millions of assays every year to establish the safety, composition, authenticity, origin, traceability, and purity of food and other substances.
With a combination of the highest analytical quality standards and personal consulting from one primary contact at Eureka, you gain the assurance you need when trading your products. Eureka Labs is dedicated to offering the highest-quality services, precise results in a timely manner, and professional advice from its highly qualified staff members. The data’s reliability and precision enable users to make appropriate decisions, satisfy their escalating requirements for safety and quality, and meet the growing demands of regulatory bodies around the world.
Eureka offers a portfolio of more than 700 analytical techniques for assessing the identification, content, authenticity, origin, and purity of biological substances and products, along with cutting-edge food and pharmaceutical analysis.
Furthermore, we can offer a wide range of services to meet your expectations for NPOP-compliant testing of organic products as well as those of other exporting nations like the EU, USA, Japan, Korea, Australia, New Zealand, Canada, Biosuisse, and others.